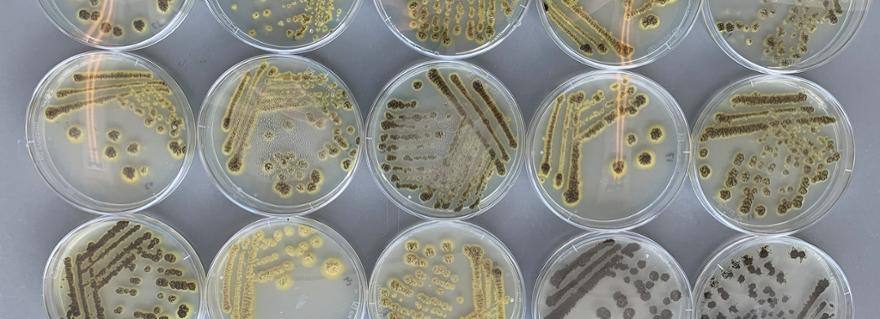

Grant for research into fungus that could make vegan cheese cheaper and more sustainable
Leiden researchers and partners have been awarded a 1.3-million-euro grant to produce milk protein for vegan cheese using fungi. While this process is not new, the use of another fungus could make the protein cheaper and more sustainable.
Considerable lab work is still needed before the vegan cheese appears on the supermarket shelves. The consortium is researching how fungi can produce caseins, the proteins found in milk. The primary proteins in cheese, caseins are not naturally produced by the fungus, but by adding a piece of DNA the fungus can be enabled to do so. Further research is needed to optimise the process.
Although this approach is often used, what is new about this project is the fungus itself – the name of which cannot yet be disclosed. This has never been used to produce casein. ‘We need to further develop the genetic and fermentation techniques for this fungus’, says Arthur Ram. He is Professor of Fungal Genetics and Biotechnology and the project’s principal investigator.
Grant from NWO and Cellular Agriculture Netherlands
The FungCows: Fungal Cell Factories for generation of cow-free products consortium has been awarded 1.3 million euros from the Dutch Research Council’s (NWO) National Growth Fund for Cellular Agriculture and the Dutch Cellular Agriculture Foundation. The aim of the programme is to support the emerging cultured meat and precision fermentation sector.
FungCows will use precision fermentation, a technology that programmes genetically modified microorganisms such as fungi to produce specific proteins, fats or flavourings.
Fungus as an alternative to cows
One major advantage of the fungus used in this project is that it can grow on grass, a cheaper carbon source than those required by other fungi. ‘This cheesemaking method also has a smaller carbon footprint than the method using cow’s milk’, says Ram. ‘Cows need large amounts of space, eat and drink a lot and emit a large quantity of CO2. Globally, there are many regions where intensive agriculture is not feasible, but where grass can grow that can be used for this fungus.’ As a result producing casein in this way would not compete with other crops.
Ensuring the fungus produces protein
A range of partners are working together in the FungCows consortium. The Leiden researchers are working with the Bioscienz biotech company on the genetic modification of the fungi. Avans University of Applied Sciences is helping by developing bioinformatics methods to analyse how the fungus responds to the production of animal proteins. Together, the researchers aim to ensure that the fungus produces the milk protein as efficiently as possible.
HAN University of Applied Sciences (HAN Biocentre) is focusing on optimising the fermentation process. Its main task is selecting the most suitable growth medium and fermentation conditions to ensure the best growth in the bioreactor and the maximum protein yield. Biotechnology Fermentation Facility is responsible for ensuring that the process can be scaled up, enabling biotech company Those Vegan Cowboys to produce cheese for the market. Ram expects it to take at least four years before we can sample cheeses made with this fungus.
New host
Ram is delighted with the grant and enthusiastic about the project. ‘I’ve got over 25 years of experience working with model fungi [a species that has already been studied intensively]. Discovering a new host is a huge challenge. And it’s exciting to work with partners and companies to apply the knowledge we’ve built up over the years to the development of vegan cheese.’
